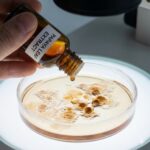
Papaya bladekstrakt symboliseret ved nogle papayadråber der kommes i en petriskål.
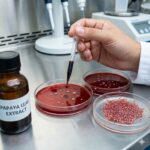
Papaya bladekstrakt symboliseret ved petriskåle med rød masse i et laboratoriemiljø.

Papaya bladekstrakt og kræft
Resumé om Papaya bladekstrakt
Virkning:
- Papaya bladekstrakt virker primært ved at stimulere produktionen af blodplader og modulere immunforsvaret via aktive enzymer som papain. Studier viser desuden en direkte hæmmende effekt på væksten af visse kræftceller og en evne til at fremme celledød.
Potentiale ved kræft:
- Det væsentligste potentiale er evnen til at modvirke kemoterapi-induceret fald i blodplader, hvilket kan sikre et stabilt behandlingsforløb uden pauser. Samtidig tyder forskning på, at ekstraktet kan angribe kræftceller selektivt uden at skade det raske væv.
Vigtigste begrænsning:
- De fleste beviser for den direkte effekt på tumorer er stadig baseret på laboratorie- og dyreforsøg, og der mangler store kliniske studier på mennesker.
- Kan desuden interagere med blodfortyndende medicin.
Hvad er Papaya bladekstrakt

Papaya bladekstrakt udvindes af bladene fra papayatræet (Carica papaya), en plante der er velkendt for sine frugter, men hvor bladene indeholder en unik sammensætning af aktive stoffer.
I modsætning til frugten, som er rig på sukkerstoffer, indeholder bladene høje koncentrationer af proteolytiske enzymer (proteinnedbrydende) såsom papain og chymopapain, samt alkaloider som carpain, flavonoider og fenoliske forbindelser.
Det er disse specifikke komponenter i bladene, der gør dem interessante i medicinsk sammenhæng, særligt i forhold til immunmodulation og cellebeskyttelse. Det er vigtigt at skelne mellem ekstraktet fra bladene og selve frugten, da de terapeutiske profiler er væsentligt forskellige.
Historie
Gennem tiden har udtræk fra papayablade været anvendt i tropiske regioner som Sydøstasien, Afrika og Sydamerika som en del af folkemedicinen. Det har traditionelt været benyttet mod febersygdomme, især denguefeber, hvor det er kendt for sin evne til hurtigt at hæve antallet af blodplader hos patienter.
Oprindeligt stammer planten fra Mellemamerika, men dens medicinske anvendelse har spredt sig globalt i takt med, at dens egenskaber er blevet observeret og videregivet gennem generationer.
Virkningsmekanismer
Papaya bladekstrakt fungerer gennem flere biologiske veje, der tilsammen skaber dets terapeutiske effekt. En central mekanisme er evnen til at øge produktionen af signalstoffet Interleukin-11 (IL-11) og trombopoietin i leveren, hvilket stimulerer knoglemarven til at producere flere megakaryocytter – forstadiet til blodplader. Dette er den primære årsag til, at ekstraktet kan modvirke fald i blodpladetal.
På celleplan har ekstraktet vist sig at kunne inducere apoptose (programmeret celledød) i unormale celler. Dette sker blandt andet ved at påvirke cellecyklussen, så delingen af kræftceller bremses, typisk i G2/M-fasen. De proteolytiske enzymer, papain og chymopapain, menes desuden at kunne nedbryde den fibrin-kappe, som kræftceller ofte gemmer sig bag for at undgå immunforsvarets angreb.
Endelig virker ekstraktet immunmodulerende ved at skifte immunresponsen mod et såkaldt Th1-respons. Det betyder, at det øger frigivelsen af specifikke cytokiner (som IL-12 og Interferon-gamma), der hjælper immunforsvaret med mere effektivt at genkende og angribe patogener og tumorceller [1].
Potentiale ved kræft

Støtte under kemoterapi
Det mest dokumenterede og umiddelbare potentiale for kræftramte er brugen af papaya bladekstrakt som støttebehandling under kemoterapi.
Mange kemoterapeutiske midler ødelægger hurtigtdelende celler, hvilket går hårdt ud over knoglemarven og medfører trombocytopeni (farligt lavt antal blodplader). Dette kan tvinge behandlere til at udskyde livsvigtige behandlinger eller reducere dosis.
Her har papaya bladekstrakt vist et betydeligt potentiale til at stabilisere og hæve blodpladetallet, så behandlingen kan fortsætte uforstyrret.
Selektiv cytotoksicitet
Ud over denne støttende funktion er der et stort potentiale i ekstraktets direkte effekt på kræftceller. In vitro (i reagensglas/ petriskål) studier har vist lovende resultater over for kræftcellinjer fra blandt andet bryst, lunge, prostata, bugspytkirtel og livmoderhals.
Potentialet ligger her i en “selektiv cytotoksicitet”, hvor ekstraktet ser ud til at dræbe kræftceller uden at skade de normale, raske celler i samme grad.
Dette tilskrives dels de antioxidante egenskaber, der beskytter raskt væv, og dels den specifikke enzymatiske aktivitet, der angriber kræftcellens overflade [2].
Tysk komplementær behandling
I Tyskland er der en stærk tradition for såkaldt komplementær onkologi, hvor man kombinerer det bedste fra naturmedicinen med konventionel sygehusbehandling.
Her har enzymer fra papaya, særligt papain, længe været en fast bestanddel af systemisk enzymterapi. Tyske behandlere anvender disse enzymer til at dæmpe inflammation og mindske bivirkninger fra stråle- og kemoterapi, eksempelvis skader på slimhinderne.
Denne kliniske erfaring har banet vejen for, at man nu også målrettet anvender bladekstraktet til patienter med lave blodpladetal, for at sikre, at deres krop er stærk nok til at gennemføre det planlagte kemoforløb uden pauser. [5]
Fordele ved papaya bladekstrakt
En væsentlig fordel ved papaya bladekstrakt er, at det er et naturligt produkt, der generelt tåles godt af kroppen. Det tilbyder en dobbeltvirkning, idet det støtter kroppen ved at rydde op i inflammation og styrke blodværdierne, samtidig med at det angriber sygdomsprocesserne.
For patienter med fordøjelsesproblemer – hvilket ofte følger med kræftbehandling – kan indholdet af papain være en ekstra fordel, da dette enzym hjælper med at nedbryde proteiner og derved letter optagelsen af næring. Det er desuden relativt let at indtage, enten som te, saft eller i kapselform, hvilket gør det nemt at implementere i en daglig rutine.
Ulemper og begrænsninger

Den primære smagsmæssige ulempe er, at ren saft fra papayablade er ekstremt bitter, hvilket kan være udfordrende for personer, der i forvejen lider af kvalme eller appetitløshed. Kapsler kan afhjælpe dette, men smagen af te eller ekstrakt kan være gennemtrængende.
En vigtig medicinsk begrænsning er interaktionen med blodets størkningsevne. Selvom det øger antallet af blodplader, kan det i nogle tilfælde påvirke virkningen af blodfortyndende medicin uforudsigeligt.
Derudover er biotilgængeligheden (hvor meget kroppen optager) afhængig af ekstraktionsmetoden. Te har en anden profil end alkoholekstrakter, hvilket kan gøre det svært at sikre en præcis, standardiseret dosis hver gang [4].
Kliniske studier

Forskningen i papaya bladekstrakt er i vækst, især inden for de seneste år. Der foreligger solide kliniske data fra studier af denguefeber, som beviser effekten på blodplader.
Inden for kræft er der gennemført flere in vivo (i levende organismer) studier på dyr samt mindre caseserier på mennesker.
Et interessant casestudie fra 2022 beskrev en patient med Glioblastom (hjernekræft), der led af svær kemoterapi-induceret trombocytopeni. Efter opstart på Papaya bladekstrakt steg patientens blodpladetal markant fra kritisk lave niveauer til normale niveauer, hvilket muliggjorde fortsat behandling.
Systematiske reviews af dyrestudier bekræfter ligeledes, at ekstraktet kan beskytte mod bivirkninger fra stoffer som carboplatin og busulfan [2].
In vitro (i reagensglas/ petriskål) studier har desuden demonstreret, at ekstraktet kan hæmme væksten af ovariekræftceller ved at stoppe deres cellecyklus [3].
Sikkerhed

Høj tolerance:
Papaya bladekstrakt betragtes generelt som sikkert ved anbefalede doser og kortvarig brug. Toksikologiske studier indikerer, at det har en lav giftighed.
Forsigtighed ved latexallergi:
Man skal være opmærksom på, at planten tilhører familien af latex-producerende planter, så personer med latex-allergi kan opleve krydsreaktioner.
Gravide og ammende:
Gravide bør udvise stor forsigtighed eller helt undgå ekstraktet, da visse stoffer i papaya kan stimulere livmoderen.
Interaktioner:
Den vigtigste sikkerhedsforanstaltning gælder dog interaktioner med medicin. Hvis man tager blodfortyndende medicin (f.eks. Warfarin eller Magnyl) eller diabetesmedicin, skal man konsultere sin behandler, da ekstraktet kan forstærke eller ændre effekten af disse lægemidler.
Dispensering og anvendelse

Anvendelsen varierer afhængigt af produktet, men følgende er typiske fremgangsmåder:
- Frisk bladsaft: Friske blade vaskes, knuses og presses. Dette betragtes ofte som den mest potente form, men smagen er meget bitter.
- Te (Infusion): Tørrede eller friske blade overhældes med kogende vand og trækker i 10-15 minutter. Dette er en mildere form, men god til vedligeholdelse.
- Standardiserede kapsler/tabletter: Dette sikrer en mere ensartet dosis og eliminerer smagsproblemer. Følg altid producentens eller din behandlers anvisning.
- Dosis-titrering: Det anbefales ofte at starte med en lav dosis og langsomt øge den for at se, hvordan maven reagerer.
- Indtag: Tages gerne i forbindelse med måltider for at mindske risikoen for maveirritation.
Konklusion

Papaya bladekstrakt repræsenterer en lovende, komplementær mulighed for kræftramte, især som et redskab til at håndtere de hæmatologiske bivirkninger ved kemoterapi.
Dets evne til at støtte blodpladeproduktionen er velunderbygget, og de immunmodulerende egenskaber kan bidrage til en styrket krop under et sygdomsforløb.
Mens vi stadig afventer store, definitive humane studier af den direkte kræftdræbende effekt, viser den nuværende forskning, at ekstraktet har et bredt terapeutisk vindue og kan anvendes sikkert af de fleste, så længe man er opmærksom på medicininteraktioner.
Tilbage til Kosttilskud
Links
[1] Delving into the Therapeutic Potential of Carica papaya Leaf against Thrombocytopenia (PubMed, 2022)
- Indhold: Et omfattende review, der gennemgår mekanismerne bag ekstraktets evne til at øge blodplader og dets immunmodulerende effekter.
[2] A Case Study Using Papaya Leaf Extract to Reverse Chemotherapy-Induced Thrombocytopenia in a GBM Patient (PubMed, Integrative Cancer Therapies, 2022)
- Indhold: Et klinisk casestudie der viser, hvordan en kræftpatient succesfuldt genvandt normale blodpladetal ved brug af papaya bladekstrakt under kemoterapi.
[3] Effect of Ethanolic Extract of Carica papaya Leaves and their Cytotoxicity and Apoptotic Potential in Human Ovarian Cancer Cell (Pharmacognosy Magazine, 2021)
- Indhold: Et in vitro (i reagensglas) studie, der demonstrerer ekstraktets evne til at dræbe æggestokkræftceller ved at inducere apoptose og stoppe cellecyklus.
[4] Carica papaya L. Leaf: A Systematic Scoping Review on Biological Safety and Herb-Drug Interactions (Frontiers in Pharmacology, 2021)
- Indhold: En systematisk gennemgang af sikkerhedsprofilen, der konkluderer, at korttidsbrug er sikkert, men advarer om interaktioner med visse lægemidler.
[5] Enzymtherapie (Krebsgesellschaft NRW, 2025)
- Indhold: Officiel patientinformation fra den tyske kræftforening i NRW. Beskriver hvordan enzymer som papain (fra papaya) anvendes komplementært i Tyskland for at mindske bivirkninger ved kemo- og stråleterapi samt styrke immunforsvaret.
Siden er oprettet:
d. 14.12.25
❤
Hvad du læser på Jeg har Kræft er ikke en anbefaling. Søg kompetent vejledning.
Forfatterinfo og professionelt grundlag

Samtlige artikler på dette site er udarbejdet og valideret af undertegnede, Hanne Kjær Uhlig. Jeg er uddannet sygeplejerske (1975, med klinisk erfaring frem til 2013) og cand.arch. (1983, med speciale i industriel design), samt underviser i en årrække på DTU (Danmarks Tekniske Universitet).
Efter tabet af min mor til kræft i 2000 og min egen kræftdiagnose i 2024, stiftede jeg dette non-profit informationssite Jeg har Kræft.
Målet er at bruge min analytiske og akademiske systematik til at bringe overblik, sikkerhed og videnskabelig dokumentation ind i feltet for integrativ, komplementær og alternativ kræftbehandling. Samtidig benyttes min sundhedsfaglige erfaring til at gøre artikler patientnære – og vedkommende.
Artiklens kendetegn:
- Klinisk og personlig ballast: Skabt ud fra en kombination af årtiers erfaring som sygeplejerske og egne oplevelser som patient og pårørende.
- Videnskabelig systematik: Indholdet bygger på systematisk research af medicinske databaser samt kliniske forsøg. Artiklerne er konsekvent underbygget med kildehenvisninger under Links.
- Uafhængigt non-profit projekt: Driften sikres via frivillige bidrag og medlemskaber gennem Støtteforeningen Jeg har Kræft. Sitet er fuldstændig uafhængigt af kommercielle producentinteresser og arbejder udelukkende for at fremme kræftramtes livskvalitet.
- Støtteforeningens bestyrelse består af:
- Formand: Hanne Kjær Uhlig , sygeplejerske og cand.arch.
- Kasserer: Jens Ottosen-Støtt, jurist
- Medlem: Thomas Kjær Uhlig, speciallæge, øjensygdomme
- Medlem: Martin Kjær Uhlig, cand.merc.aud.
Fællesskab: Bliv medlem af Facebookgruppen: Jeg har Kræft – Hvad kan jeg gøre?
❤
Hvad du læser på Jeg har Kræft er ikke en anbefaling. Søg kompetent vejledning.

